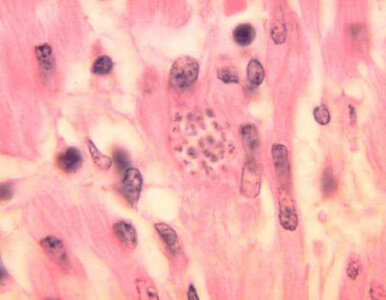
Miniatura: „Choroba całujących pluskiew”...

9 września 2025
-
800+ tylko dla pracujących obcokrajowców. Rząd przyjął projekt ustawy
Rząd przyjął projekt ustawy regulujący kwestie świadczeń dla obcokrajowców. Zgodnie z propozycją z programów 800+, Dobry start, Aktywny rodzic będą mogli korzystać jedynie pracujący obcokrajowcy.
KrajPolityka
-
Drony na terenie Polski. Politycy dla „Wprost”: Rosjanie nas sprawdzają
– Rosjanie po prostu testują nasze systemy obronne i sprawdzają, jak to u nas działa – mówi „Wprost” Paweł Bliźniuk (KO), odnosząc się do ostatnich incydentów z dronami. Mariusz Błaszczak (PiS) podkreśla, że „Polska powinna się zbroić”.
Opinie i komentarzePolitykaTylko u Nas
Aleksandra CieślikWideo
-
Macron wybrał nowego kandydata na premiera. To znany polityk
Prezydent Francji Emmanuel Macron podał nazwisko polityka wskazanego jako kandydat na nowego premiera. To dotychczasowy minister sił zbrojnych, Sebastien Lecornu.
PolitykaŚwiat
-
Weź odpadki ze śniadania i przygotuj turbo odżywkę. Kwitnienie do listopada masz jak w banku
Poznaj prosty przepis na domową odżywkę do rozchodnika, która przedłuży jego kwitnienie. Sprawdź, jak prawidłowo nawozić i pielęgnować roślinę, by cieszyć się pięknymi kwiatami aż do listopada.
Życie
Magda Grefkowicz
-
Polska zamyka granice, Białoruś protestuje. „Nielegalne działania”
Białoruski resort spraw zagranicznych oburzony. Chodzi o decyzję Polski związaną z zamknięciem granic z Białorusią na czas trwania wojskowych manewrów Zapad-2025. Wydano w tej sprawie komunikat, a do siedziby białoruskiego MSZ wezwano...
PolitykaŚwiat
-
Mieszam trzy składniki i czyszczę WC. Toaleta pachnie i błyszczy bez szorowania
Zrób tani i skuteczny domowy środek do toalety z trzech popularnych składników. Dowiedz się, jak działa, jak go stosować i kiedy sięgnąć po mocniejsze metody.
Życie
Ewa Jagalska
-
„Białe grzyby na łące” wyrokiem śmierci. Kobieta nie żyje
Starsze małżeństwo udało się na spokojne grzybobranie. Gdy na łące włożyli do koszyków jasne okazy, najprawdopodobniej nie spodziewali się, że ich zjedzenie skończy się tragicznie.
KrajŻycie
-
Ruch Narodowy przeciwko edukacji zdrowotnej. Krytykują MEN
Ruch Narodowy na Opolszczyźnie zorganizował pikietę przeciwko przedmiotowi edukacja zdrowotna. Działacze krytykowali zmiany wprowadzane przez Barbarę Nowacką. MEN uruchomiło z kolei kampanię informacyjną broniącą nowego przedmiotu.
PolitykaKraj
-
Węże wdarły się do szpitali. Lekarze ogłosili ogólnokrajowy strajk
Nigeria mierzy się z niecodziennym problemem. Jak donosi tamtejsze stowarzyszenie lekarzy rezydentów, pracownicy szpitali walczą z plagą... węży. Być może brzmi to kuriozalnie, ale sprawa jest śmiertelnie poważna.
ŻycieŚwiat
-
Zmiany w przepisach budowlanych 2025 grożą wyższymi kosztami budowy – styropian zagrożony!
Nowelizacja warunków technicznych może ograniczyć stosowanie styropianu w ociepleniach. Sprawdź, co oznacza dla inwestorów i kosztów budowy.
Życie
Magda Grefkowicz
-
Koniec rozwoju turystyki na pięknej wyspie. Została objęta ochroną
Piękna grecka wyspa otrzymała status stanowiska archeologicznego. Masowa turystyka już jej nie grozi.
Podróże
-
Akcja Uczniowska krytykuje Episkopat. W tle decyzja MEN i Nowackiej
Założyciel Akcji Uczniowskiej podczas konferencji prasowej wypowiedział się na temat edukacji zdrowotnej. Zaapelował do rodziców i nauczycieli, a działania Episkopatu nazwał „zdecydowanie skandalicznymi”.
ŻycieKraj
-
Stanowski kontra Wysocka-Sznepf. „Dobra osobiste to nie nauka ścisła”
Pozew Doroty Wysockiej-Schnepf o 100 tysięcy złotych przeciwko Krzysztofowi Stanowskiemu i Robertowi Mazurkowi otwiera trudną batalię o ochronę dóbr osobistych. Adwokat Tomasz Gołembiewski zaznacza, że rozstrzygnięcie zależy od oceny...
Opinie i komentarzeKraj
Bartosz Michalski
-
Białoruski agent w rękach ABW, dyplomata wydalony. Ostra reakcja premiera
W poniedziałek doszło do zatrzymania białoruskiego agenta. Z Polski zostanie wydalony również tamtejszy dyplomata. O sprawie poinformował premier Donald Tusk.
PolitykaKraj
-
Te trasy LOT Polacy wybierają najchętniej. Korzysta z nich połowa pasażerów
Trasy z Polski do USA to hit Polskich Linii Lotniczych LOT. Sprawdzono, na których miejsca w samolotach zapełniają się niemal całkowicie.
Podróże
-
Miliony strat rolników. Obwiniają dystrybutora nasion
Rolnikom z województwa świętokrzyskiego wyrosła pietruszka naciowa zamiast korzeniowej. Straty oszacowano na miliony złotych. Prawdopodobnie doszło do pomyłki u czeskiego dostawcy nasion.
KrajŻycie
-
Rekordowe środki z UE dla Polski. „Będziemy największym beneficjentem”
Polska ma otrzymać rekordowe wsparcie finansowe. Na obronność kraju przeznaczone zostaną ogromne środki płynące z Unii Europejskiej.
PolitykaKraj
-
Będzie kwitł jak szalony do końca listopada. Jeśli to zrobisz, nic mu nie przeszkodzi
Chcesz, by rozchodnik kwitł długo i obficie? Sprawdź 7 sprawdzonych sposobów na pielęgnację, nawożenie i przycinanie tej odpornej rośliny, dzięki którym cieszyć się nią będziesz od lata aż do listopada.
Życie
Magda Grefkowicz
-
Na tę decyzję czekały miliony Polaków. Zobaczą ją na rachunkach
Miliony Polaków odetchną. Rząd przyjął dziś ustawę o bonie ciepłowniczym i stałych cenach prądu.
EnergetykaGospodarkaFinanse i inwestycjeFirmy i rynkiBranże
Beata Anna Święcicka
-
Stolica Kataru w ogniu. Izrael zaatakował z pełną mocą
Jak wynika z informacji Reutera, w stolicy Kataru doszło do olbrzymiej eksplozji. Służby potwierdzają, że był to atak na liderów Hamasu. Z kolei AFP donosi o wybuchach w kilku miejscach Dohy.
ŚwiatPolityka
-
„Nasz nowy dom” to już nie tylko dom. Sprawdź, co się zmieni od czwartku
25 sezonów na antenie, tysiące łez i chwytające za serce historie rodzin, które dostały szansę na lepsze jutro. Tu też zajdą zmiany.
TelewizjaGwiazdyPrime time
Andrzej Kwaśniewski
-
Stolica Niemiec sparaliżowana. Blackout w Berlinie z „motywem politycznym”?
Berlin w oka mgnieniu zamienił się w czarną plamę na mapie Niemiec. Dziesiątki tysięcy mieszkańców miasta zostało bez prądu, a służby badają, czy gigantyczna awaria nie była efektem celowego ataku o podłożu politycznym.
ŚwiatŻycie
-
Plaga insektów nad polskim morzem. „Wieczorne spacery niemożliwe”
Koniec sezonu letniego nad Bałtykiem oznacza poważne problemy dla turystów. W tej miejscowości wczasowicze mają do czynienia z prawdziwą plagą.
Podróże
-
Strażak chce uratować córkę. Zamierza pobić nietypowy rekord
Łukasz Jęcz z Zielonej Góry postanowił bicyklem pokonać 2 700 km w 30 dni. To jego sposób na zebranie środków na leczenie cierpiącej na rzadką chorobę córki.
ŻycieKraj
-
Widziałeś je tysiące razy. Żółty przycisk dla pieszych ma ukrytą funkcję
Żółte przyciski na przejściach dla pieszych przyśpieszają włączenie zielonego światła. Na niektórych skrzyżowaniach pozostają mimo detekcji automatycznej. Powodem jest potencjalna awaria i czynnik psychologiczny. Dodatkowo stanowią one...
KrajMotoryzacjaŻycie
-
Groźne manewry u granic Polski. Tusk zapowiada stanowcze działania
Tuż przed rozpoczęciem rosyjsko-białoruskich manewrów Zapad-2025 Polska zapowiada zdecydowaną odpowiedź. Głos w tej sprawie zabrał premier Donald Tusk.
PolitykaKraj
-
Wypłynęły stawki Dody i Steczkowskiej. Tyle zarobią za kilkanaście minut
Kogoś jeszcze dziwią kosmiczne zarobki gwiazd? Nikogo, ale te akurat wydają się już szybować w jakimś ponadgalaktycznym wymiarze.
GwiazdyPrime timeMuzykaFestiwale/Przeglądy
Andrzej Kwaśniewski
-
Koniec rodzinnej wojny Murdochów. Lachlan przejmuje imperium medialne
Rodzina Murdochów zakończyła spór o kontrolę nad medialnym imperium. Lachlan Murdoch przejmie stery, a rodzeństwo otrzyma 3,3 mld dolarów.
GospodarkaFirmy i rynki
-
Nawrocki ostrzega przed zamiarami Putina. Wtórował mu prezydent Finlandii
We wtorek 9 września prezydent Karol Nawrocki udał się do Helsinek na spotkanie z prezydentem Alexandrem Stubbem. Podczas wspólnej konferencji prasowej podkreślał, że Polska i Finlandia są zgodne w ocenie charakteru i zamiarów Władimira...
ŚwiatKrajPolityka
-
Te linie są najbardziej przyjazne zwierzętom. Jak wypadły Ryanair i LOT?
Wielu europejskich przewoźników pozwala na podróżowanie ze zwierzętami domowymi. W rankingu najbardziej przyjaznych pupilom linii lotniczych nie znajdziemy jednak tych najtańszych.
Podróże
-
Rodzice nadużywają L4 na dziecko? „Dodatkowe wolne"
Początek roku szkolnego to czas, gdy średnia liczba L4 na opiekę nad dzieckiem rośnie do poziomu 9-11 proc. - informuje Conperio. Nawet jedna trzecia zwolnień lekarskich tego typu może być jednak nadużywana.
Finanse i inwestycjeFirmy i rynki
Radosław Święcki
-
Śmierć trzyosobowej rodziny w wypadku na A1. Nagły zwrot ws. procesu Sebastiana M.
Sąd zdecydował, że sprawa tragicznego wypadku na autostradzie A1, w którym zginęli rodzice i ich pięcioletni syn, trafi do mediacji. Ewentualne porozumienie może, ale nie musi zostać uwzględnione.
KrajŻycie
-
Skandaliczny komunikat ukraińskiego IPN. Jest reakcja po interwencji polskiego MSZ
Ministerstwo Spraw Zagranicznych Polski zareagowało po nieprawdziwym komunikacie ukraińskiego IPN na temat zbrodni w Puźnikach. Wiadomość została poprawiona, choć wciąż może nie być w pełni satysfakcjonująca.
ŚwiatKrajPolitykaHistoria
-
„Zakazane” zdjęcia Andrzeja Dudy. Fotograf ujawnił kulisy
Fotograf opisał kulisy współpracy z Andrzejem Dudą. Były takie zdjęcia, których były już prezydent nie chciał publikować.
KrajOpinie i komentarzePolitykaŻycie
-
Trio detektywów wróciło w kultowym serialu. Od dziś nowe odcinki
Na Disney+ wrócił kultowy już serial z Seleną Gomez w jednej z głównych ról. Czego spodziewać się możemy po nowej odsłonie?
SerialePrime time
-
Nowe przepisy od 2026 r. Urlop i dodatki także dla zleceniobiorców
Nowelizacja Kodeksu pracy odmieni życie milionów Polaków. Staż pracy obejmie także „śmieciówki” i działalność gospodarczą.
Branże
-
4 seriale Netfliksa do binge'owania w tym tygodniu
Szukacie czegoś na wieczorny seans? Netflix właśnie serwuje 4 seriale, które pochłoną was od pierwszego odcinka. Sprawdźcie, co warto obejrzeć w tym tygodniu.
SerialePrime time
-
Kursy walut 9 września 2025. Po ile dolar, euro, funt i frank?
Kursy walut 9 września 2025. Po ile dolar, euro, funt i frank?
Finanse i inwestycjeFirmy i rynkiGospodarkaBranże
Radosław Święcki
-
Nie beż, nie szarość… Zobacz, co będzie hitem w polskich domach w przyszłym roku
Nie wiesz, jakie kolory wybrać do salonu? Eksperci mają odpowiedź – te trzy odcienie odmieniają wnętrza i nastroje.
Życie
Ewa Jagalska
-
Politycy PiS uderzyli w Tuska. „Polska jest okradana przez UE”
Szymon Szynkowski vel Sęk i Ryszard Czarnecki poruszyli kwestię unijnego budżetu. Poseł PiS nie ukrywał swojego rozczarowania i zwrócił uwagę na „bardzo niepokojący element”. Dostało się też Radosławowi Sikorskiemu.
Opinie i komentarzePolitykaKraj
-
Roszady w Sejmie. Czworo nowych posłów złożyło ślubowanie
We wtorek 9 września w Sejmie zaprzysiężono czworo nowych posłów. Zastąpili oni parlamentarzystów, którzy przeszli do Kancelarii Prezydenta.
KrajPolitykaŻycie
-
Apple pod presją Trumpa. Nowy iPhone 17 droższy niż dotąd?
Apple pokaże iPhone’a 17, w tym ultracienki model Air. Premiera budzi emocje, bo na ceny mogą wpłynąć cła i presja Donalda Trumpa.
TechnologieGospodarka
-
O tym pytaniu do Świątek zrobiło się głośno. Abramowicz reaguje
Daria Abramowicz odniosła się do pytania, które na jednej z konferencji prasowych usłyszała Iga Świątek. – Dało jakąś informację – zaznaczyła psycholożka.
TenisSportŻycie
-
Znika znana opłata w Ryanair. Turyści zauważą zmianę jeszcze w tym roku
Ryanair kończy z tradycyjnymi kartami pokładowymi i nie zamierza już przekładać tej zmiany na później. Turyści zapomną o znanych opłatach, a wydrukowany bilet nic im nie da.
Podróże
-
Gorące kryminały i thrillery w TV. Jeden to hit premium!
Na brak emocji tej jesieni na pewno nie będziemy narzekać. Pod warunkiem, że wieczory spędzimy z pilotem w ręku.
SerialeTelewizjaPrime time
-
Klienci Biedronki zwietrzyli interes. Te produkty sprzedają w sieci
Biedronka od niemal 10 lat oferuje w ramach swojej akcji lojalnościowej maskotki pod nazwą „Gang...". Klienci zwietrzyli interes i odsprzedają zgromadzone pluszaki w sieci. Ceny bywają kosmiczne.
Finanse i inwestycjeFirmy i rynki
-
Ropa znów w górę. Krótkie obrady OPEC+ wywołały skok cen
OPEC+ w 11 minut zgodził się na zwiększenie wydobycia ropy. Decyzja natychmiast odbiła się na giełdach – ceny surowca idą w górę.
Gospodarka
-
Katarzyna Zillmann nie kryła wzruszenia. „Mam ochotę się popłakać”
Wicemistrzyni olimpijska z Tokio nie potrafiła ukryć emocji. Tuż przed startem w „Tańcu z gwiazdami” zdradziła, co myśli o innych uczestniczkach.
GwiazdyTelewizjaPrime time
Andrzej Kwaśniewski
-
Od duchów po psychopatycznych morderców – najstraszniejsze seriale na Netflix i HBO Max
Lubisz dreszczyk emocji? Zarówno Netflix, jak i HBO Max mają w ofercie seriale, które przyprawią cię o gęsią skórkę. To lista najlepszych horrorów, które musisz zobaczyć.
SerialePrime time
-
Pies je trawę i wymiotuje? Nie powinno się tego lekceważyć
Wymiotujący pies to podstawa do tego, by zastanowić się nad pójściem do weterynarza. Nawet jeżeli nastąpi to po zjedzeniu trawy, badania sugerowałyby konsultację ze specjalistą.
ŻycieNaukaEkologia
-
PKP wprowadza rewolucję. Czy to koniec tradycyjnych rozkładów jazdy?
PKP rozpoczęło test nowego udogodnienia na przystankach kolejowych. Od nowego roku pasażerowie skorzystają z niego w całej Polsce.
Podróże
-
Senator już bez pracy, pojawił się mocny wpis. „Nowy kierunek polityczny wzbudza zaniepokojenie”
Urszula Demkow, Marek Kos i Wojciech Konieczny zostali odwołani z funkcji wiceministrów zdrowia. Decyzja Donalda Tuska nie spotkała się z zadowoleniem PPS. Do kierownictwa MZ dołączyli Katarzyna Kęcka i Tomasz Maciejewski.
PolitykaKraj
-
Mały samolot rozbił się pod Żywcem. Są ofiary śmiertelne
Dwie osoby zginęły w wyniku wypadku lotniczego, do którego doszło we wsi Lipowa – podało RMF FM. Rozbił się lekki samolot sportowy.
KrajŻycie
-
Polska trzecim rynkiem dla słonecznej wyspy. Turyści wcale nie oszczędzali
Więcej turystów z Polski, którzy wydali dużo więcej pieniędzy niż rok wcześniej – tak można podsumować pierwsze półrocze w maltańskiej turystyce, biorąc pod uwagę gości z Europy. Wkrótce polskie lotniska zaoferują więcej połączeń na ten...
Podróże
-
Bezrobocie w Polsce. Kolejne niepokojące dane
Stopa bezrobocia w sierpniu wyniosła 5,5 proc. - wynika ze wstępnych danych resortu pracy. To kolejny wzrost na przestrzeni ostatnich miesięcy.
Finanse i inwestycjeFirmy i rynkiGospodarka
Radosław Święcki
-
Strategiczna komunikacja dla branży. ETTO COMMS i PSNM łączą siły na rzecz promocji zrównoważonego transportu
ETTO COMMS i Polskie Stowarzyszenie Nowej Mobilności (PSNM) nawiązały współpracę w celu stworzenia nowego wymiaru komunikacji branży zeroemisyjnego transportu w Polsce. ETTO COMMS jako partner Kongresu Nowej Mobilności 2025, stworzy...
Firmy i rynkiTransport
-
Prof. Bugaj: Mamy deficyt, który może zabić. Rząd nie robi tego, co powinien zrobić
– Mamy deficyt, w dawce, która może zabić. Do tego mamy otoczenie zewnętrzne, które powinno nas skłaniać do kontrolowania sytuacji budżetowej. Ostatnio czytałem artykuł analityka ukraińskiego, a właściwie międzynarodowego, który rysuje...
KrajPolitykaGospodarkaTylko u NasPremiumTygodnik Wprost
Eliza Olczyk
-
Polacy ruszą do głosowania. Startuje wielki plebiscyt
Od poniedziałku 8 września widzowie i czytelnicy mogą głosować na swoich telewizyjnych faworytów.
GwiazdyTelewizjaSerialePrime time
-
Emerytura i renta z dodatkiem. ZUS wypłaca kolejne świadczenie
ZUS wypłaca dodatek dla sieroty zupełnej – ponad 650 zł miesięcznie. Świadczenie przyznawane jest bez względu na wiek, ale na określonych zasadach.
Branże
-
Stephen King ujawnia listę swoich 10 ulubionych filmów
Stephen King, autor takich powieści jak Zielona mila czy Skazani na Shawshank, ujawnił na X swoją listę 10 ulubionych filmów wszech czasów – bez żadnej adaptacji własnych książek.
Prime time
-
„Choroba całujących pluskiew” rozprzestrzenia się. Zarażonych 280 tys. osób?
Wywoływana przez tzw. całujące się pluskwy choroba Chagasa pojawia się w kolejnych regionach USA. Centrum Kontroli i Zapobiegania Chorobom (CDC) donosi o potwierdzonych przypadkach już w 8 stanach.
ŚwiatŻycie
-
Wysocka-Schnepf „chce się spotkać w sądzie” ze Stanowskim. „Wolę iść siedzieć, niż przeprosić”
Dorota Wysocka-Schnepf domaga się od Krzysztofa Stanowskiego i Roberta Mazurka po 100 tys. zł. Założyciel Kanału Zero w obszernym filmie odniósł się do wszystkich kwestii poruszonych w pozwie.
KrajOpinie i komentarze
-
„Milionerzy” nie przyciągnęli milionów. Jak sobie radzą?
Już po kilku pierwszych odcinkach wiadomo, jak sobie radzą „Milionerzy” po przeprowadzce do Polsatu.
TelewizjaPrime time
-
Będzie dalsze mrożenie cen prądu? Dziś decyzja rządu
Podczas dzisiejszego posiedzenia rząd przyjmie ustawę przewidującą m.in. mrożenie cen prądu do końca roku. Minister energii Miłosz Motyka jest przekonany, że tym razem prezydenckiego weta nie będzie.
Finanse i inwestycjeGospodarkaBranże
-
Poszukiwania złotego pociągu „utknęły”? „Trzeba byłoby zrobić odwierty”
Złoty pociąg wciąż rozpala wyobraźnię. Joanna Lamparska przekazała, na jakim etapie są obecnie poszukiwania grupy „Złoty Pociąg 2025”.
KrajŻycieHistoria
-
Od dziś rewolucja na polskim lotnisku. Znika uciążliwy limit w bagażu
Kolejne lotnisko w Polsce pozwoli na zabranie ze sobą większej liczby płynów w bagażu podręcznym. W Poznaniu kontrola bezpieczeństwa przebiegnie sprawniej.
Podróże
-
Awantura o „Taniec z Gwiazdami”. Narzeczona Hakiela uderza w Polsat
Wielka burza wokół jubileuszu „Tańca z Gwiazdami”. Partnerka jednego z najpopularniejszych tancerzy w historii show nie przebiera w słowach.
GwiazdyTelewizjaPrime time
Andrzej Kwaśniewski
-
Utytułowana tenisistka ocenia emocje Igi Świątek. „Może dlatego tak ją to zabolało”
Nerwowe konferencje prasowe i pokrzykiwanie podczas meczów sztabu Igi Świątek to powód do zmartwień? Zupełnie innego zdania jest legenda tenisa Justine Henin.
TenisSportOpinie i komentarzeKrajŚwiat
-
Polskie gwiazdy na premierze serialu „Breslau”. Od stylizacji może zakręcić się w głowie
W warszawskim Teatrze Polskim odbyła się uroczysta premiera polskiego serialu oryginalnego Disney+ „Breslau”. Na czerwonym dywanie, który na tę okazję zmienił kolor na turkusowy, brylowała obsada serialu, m.in. Sandra Drzymalska i Tomasz...
SerialeGwiazdyPrime time
-
Nie żyje znany polski grafik i projektant. Miał 51 lat
Odszedł wyjątkowy artysta, którego kreatywność nie znała limitów ni ograniczeń. Miał zaledwie 51 lat.
GwiazdyPrime timeSztuka/Foto
-
Nie hortensja, a piątak. Nie ma wymagań, długo kwitnie do późnej jesieni
Pentas, czyli piątak lancetowaty, to krzew o gwiaździstych kwiatach. Kwitnie całe lato i jesień. Zobacz, jak go pielęgnować i bezpiecznie zimować.
Życie
Magda Grefkowicz
-
Szalony quiz ortograficzny. Aby uniknąć wpadki, uważnie czytajcie pytania!
Quiz ortograficzny na dobre rozpoczęcie dnia! Zachowajcie czujność i uważnie czytajcie pytania, bo to może uchronić Was od wpadki.
EdukacjaKrajŻycieQuiz
-
Rząd ulży tej grupie emerytów. Już nie będą musieli spowiadać się ZUS
Szykuje się dobra zmiana dla tzw. wcześniejszych emerytów. Zakłada ona, że grupa ta nie będzie już musiała powiadamiać ZUS o wysokości swoich przychodów.
Finanse i inwestycjeGospodarkaBranże
-
Ten polski serial wraca po 17 latach! Premiera na dniach
SkyShowtime ogłosił datę premiery serialu „Glina: Nowy rozdział”, kontynuacji kultowego polskiego serialu. W obsadzie największe rodzime gwiazdy.
SerialePrime time
-
Uzdrowisko bez internetu i zasięgu. Tak będzie przez dwa miesiące
Położone niedaleko polski uzdrowisko przez dwa miesiące nie będzie miało internetu i zasięgu. To idealne miejsce na „cyfrowy detoks”.
Podróże
-
Negatywna perspektywa dla Polski. Inwestorzy zaskoczyli reakcją
Obniżka perspektywy ratingu Polski to sygnał ostrzegawczy, ale giełda, waluty i obligacje reagują spokojnie, bez gwałtownych spadków.
GospodarkaFirmy i rynki
-
Ważne informacje ws. handlu grzybami. „Ryzyko utraty zdrowia, a nawet życia”
Obrót grzybami w Polsce podlega ściśle określonym przepisom. Kupując grzyby należy zaopatrywać się wyłącznie w placówkach handlowych lub na targowiskach. W innym wypadku stwarza to ryzyko zatrucia, a nawet śmierci.
KrajŻycie
-
Podejrzany bankomat? Oto sygnały, by natychmiast przerwać transakcję
PKO BP ostrzega przed pułapkami przy bankomatach. Zwróć uwagę na szczegóły, bo jedno spojrzenie lub fałszywa nakładka może kosztować fortunę.
BranżeTechnologie
-
Ojciec Krzysztofa Dymińskiego przeczesywał rzekę. Natrafił na zatopioną łódź
Poszukujący na własną rękę zaginionego syna Daniel Dymiński dokonał niecodziennego odkrycia w Wiśle. Natrafił na pozostałości zatopionej łodzi sprzed kilkuset lat.
HistoriaWarszawaKrajŻycie
-
MEN odejdzie od głośnej reformy? Polacy podpowiedzieli Nowackiej. Sondaż
Większość Polaków opowiada się za tym, aby przywrócić prace domowe w polskich szkołach. Nowy sondaż to wyraźny sygnał dla kierownictwa Ministerstwa Edukacji Narodowej.
EdukacjaKrajŻycie
-
Kuriozalny wyrok Trybunału Konstytucyjnego. „Bezmyślność sędziów będzie kosztowna”
Obywatele żyją w słusznym, ale błędnym, przekonaniu, że najwyższe organy państwa elementarnie poważnie traktują swoje obowiązki. Że potrafią myśleć logicznie i nie robią sobie żartów z praw obywateli. Okazuje się że niezwykle długo...
Finanse i inwestycjeFirmy i rynkiKrajPolitykaTylko u NasPremium
Marek Isański
-
Będzie świeży nawet miesiąc! Ten trik z apteki uratuje każdy bukiet
Domowe dodatki, apteczne triki i sekretne sposoby florystów – oto jak sprawić, by kwiaty w wazonie cieszyły oczy nawet 4 tygodnie.
Życie
Magda Grefkowicz
-
Lokaty bankowe na trzy miesiące. Takiej stawki nie było od dawna
Wrześniowy ranking lokat bankowych na trzy miesiące przynosi spore zmiany. Na pozycję lidera wraca Lokata Powitalna od Credit Agricole. Stawka proponowana przez bank nie była widziana od miesięcy.
Finanse i inwestycjeFirmy i rynkiGospodarkaBranże
-
Silne burze i trąba powietrzna na południu Polski. „Żołnierze WOT w gotowości”
W poniedziałek 8 września wieczorem przez Polskę przeszły silne burze, miejscami przynosząc silne opady i grad. Niedaleko Wodzisławia Śląskiego zarejestrowano tornado.
PogodaKrajPolitykaŻycie
-
Przesmyk suwalski „piętą achillesową” NATO? Niepokojące prognozy
Brytyjski analityk wojskowy podaje przerażające oznaki mające świadczyć o tym, że Władimir Putin planuje inwazję na NATO. Jako miejsce wymieniany jest przesmyk suwalski.
KrajŚwiat
-
Czternasta emerytura pod lupą. Prezes ZUS nie wyklucza zmian
Czternasta emerytura wynosi w tym roku 1878,91 zł. Prezes ZUS komentuje próg 2900 zł i sugeruje, że system może wymagać zmian.
BranżeGospodarka
-
Nadciąga „zima stulecia”? Meteorolodzy nie mają złudzeń. Krótkotrwały „atak”
Zima 2025 zaskoczy? Z najnowszych prognoz pogody wynika, że śniegu będzie jak na lekarstwo. Przedstawiamy szczegóły.
KrajPogodaŻycie
-
Jeden prosty trik we wrześniu, a wiosną ogród będzie wolny od chwastów
Chcesz wiosną mieć mniej chwastów w ogrodzie? Zrób kilka prostych rzeczy jesienią. Podpowiadamy sprawdzone sposoby bez chemii.
Życie
Ewa Jagalska
-
Wyjazd do USA będzie droższy. Zmiany zauważą także Polacy
Turyści, którzy chcą wyjechać do USA, nie muszą starać się o wizę, konieczne jest jednak wyrobienie ESTA, czyli płatnej elektronicznej autoryzacji podróży. Wkrótce zapłacimy za nią dwa razy więcej niż dotychczas.
Podróże
-
Gdzie wiercić studnię? Znajdź wodę bez różdżki i uniknij kosztownych błędów
Szukasz wody na działce? Radzimy, jak znaleźć źródło bez machania różdżką i pseudonaukowych metod.
Życie
Ewa Jagalska
-
Muzyka łagodzi... chorobę lokomocyjną. Naukowcy są pewni
Czy prosta melodia może być lekarstwem na nudności i zawroty głowy podczas podróży? Najnowsze badania wskazują na to, że odpowiednia muzyka łagodzi objawy choroby lokomocyjnej. Jest jednak pewne „ale”.
NaukaŻycie